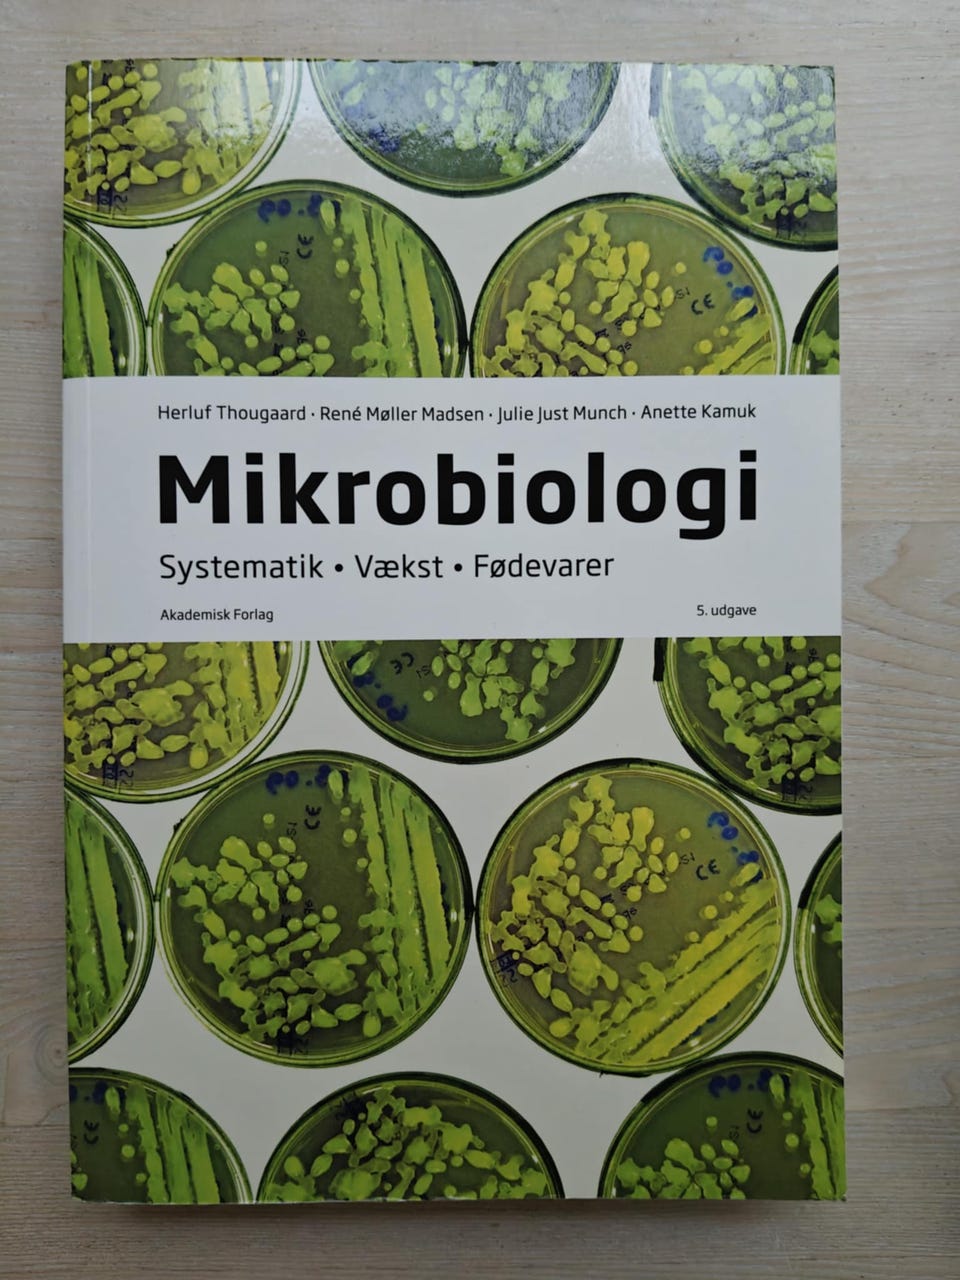
Galleribillede

Billedgalleri
(1/6)
Laborant Bøger
Til salg
1.000 kr.
Bed sælgeren om at sende med Fiks færdig! Det er trygt, hurtigt, og varen vil blive sendt til dig. Læs mere
Varebeskrivelse
Stand: Som ny - ingen synlige brugsspor
Sælger mine laborant bøger da jeg har færdiggjort studiet. Bøgerne er som nye.
Priser:
Almen, Uorganisk og Organisk Kemi 300kr
Laboratorieberegninger 200kr
Molekylærbiologi og Biokemi 300kr
Mikrobiologi 350 kr
Kemiske enhedsoperationer 100kr
Kan også købes samlet for 1000kr, giv evt. et bud.
Bøgerne kan hentes på min adresse i Bagsværd, ellers kan der aftales et fælles mødested til at overrække dem.
#Laboratorie Bøger
Bemærk: Knappen til at vise den fulde beskrivelse har kun en visuel effekt.
Brugerprofil

Du skal være logget ind for at se brugerprofiler og sende beskeder.
Log indAnnoncens metadata
Sidst redigeret: 8.12.2025 kl. 14:01 ・ Annonce-ID: 16684835